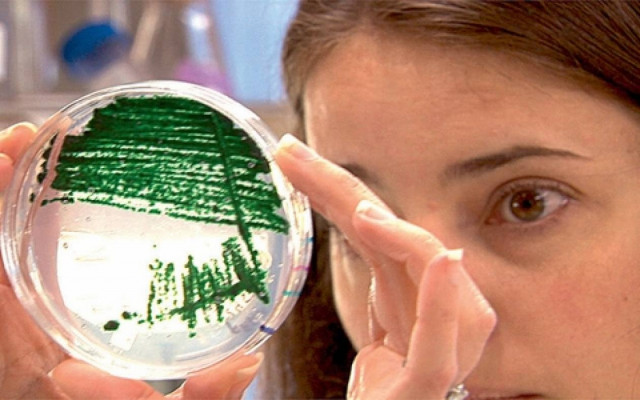
SOS: Επικίνδυνες ουσίες μέσα στο σπίτι μας. Δείτε ποιες είναι!

SOS: Επικίνδυνες ουσίες μέσα στο σπίτι μας. Δείτε ποιες είναι!
Τον κώδωνα του κινδύνου χτυπάει ο Παγκόσμιος Οργανισμός Υγείας για χημικές ουσίες οι οποίες βρίσκονται μέσα στα σπίτια μας και ευθύνονται σε μεγάλο βαθμό για πολύ σοβαρές ασθένειες όπως ο καρκίνος, η εμφάνιση άσθματος αλλά και γενετικών ανωμαλιών.
Σύμφωνα με την έρευνα που πραγματοποίησε ο Π.Ο.Υ. οι συγκεκριμένες ουσίες, οι οποίες παρεμβαίνουν στην ομαλή λειτουργία του ορμονικού συστήματος και το διαταράσσουν, βρίσκονται... παντού (!): από τα μπουκάλια που βάζουμε το νερό μέχρι τα ρούχα μας!
Οι ουσίες αυτές είναι οι εξής:
-Η βισφενόλη που εντοπίζεται στα μπουκάλια για γάλα και νερό
-οι φθαλάτες που βρίσκονται σε καλώδια, μελάνια εκτύπωσης, βερνίκια, παιχνίδια,
-οι φθαλικοί εστέρες και τα βαρέα μέταλλα που βρίσκονται μεταξύ άλλων σε απορρυπαντικά, σαμπουάν, σαπούνια, καλλυντικά ή το τρικλοζάν που εντοπίζεται σε οδοντόκρεμες, απορρυπαντικά, υφάσματα και αλλού.
Επιπλέον, αρκετές από αυτές τις ουσίες βρίσκονται σε δομικά υλικά, σε κινητά, σε ρούχα, σε παιχνίδια, στον καπνό του τσιγάρου, σε δοχεία τροφίμων/ποτών (μπουκάλια για γάλα και νερό, κουτάκια κονσέρβας, αναψυκτικού), πλαστικά, πιζάμες, αθλητικά παπούτσια, κάλτσες, σαμπουάν (gel ξυρίσματος, κρέμες σώματος, οδοντόκρεμες), καλώδια, πατώματα, κόλλες, βερνίκια, μελάνια εκτύπωσης, στεγανωτικά υλικά οικοδομής, παιχνίδια, καπνός από τσιγάρα, μαγείρεμα, ψήσιμο σε κάρβουνα, αρώματα, καλλυντικά, κραγιόν κ.λ.π.
Βεβαίως, επειδή δεν είναι δυνατόν να αποφύγουμε την χρήση όλων των παραπάνω, οι ειδικοί συμβουλεύουν να μην «τρελαινόμαστε» και να προσπαθούμε να αλλάξουμε απλές καθημερινές συνήθειες που θα μας προστατεύσουν.
Πολύ βασικό είναι να τηρούμε συστηματική καθημερινή υγιεινή, να αποφεύγουμε την χρήση πλαστικών ποτηριών για ζεστά ροφήματα, να προτιμούμε τις γυάλινες συσκευασίες και τα φρέσκα αντί για τα τυποποιημένα τρόφιμα.
























